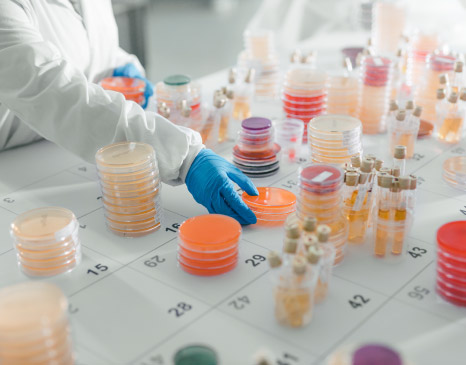
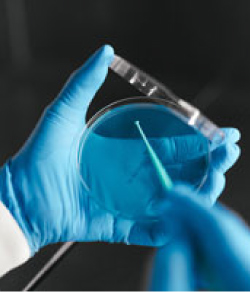

Blog tecnico
Prodotto chimico
23 Febbraio 2026
Documentazione prodotti chimici e sicurezza | Scharlau
In Scharlab, la trasparenza e la sicurezza sono pilastri fondamentali. Per questo, la nostra documentazione prodotti chimici è progettata per garantire qualità, tracciabilità e conformità normativa in ogni fase. Ogni articolo del nostro catalogo ...
AccederCosa facciamo in Scharlab?
Progettiamo

Fabbrichiamo
Distribuiamo
prodotti e servizi che aiutano la comunità scientifica a ottenere un mondo migliore.

Merce in pronta consegna
Esperti in microbiologia

Qualità ISO

Prodotto su misura

Fornitura globale per il laboratorio
Scopri la gamma completa dei prodotti che offriamo: prodotti chimici, microbiologia, vetreria, consumabile, cromatografia, strumentazione e sicurezza.
Servizio di consulenza in microbiologia
Contatta il nostro product specialist sulla microbiologia per ricevere consulenza tecnica personalizzata e completamente gratuita.

 Italia
Italia





